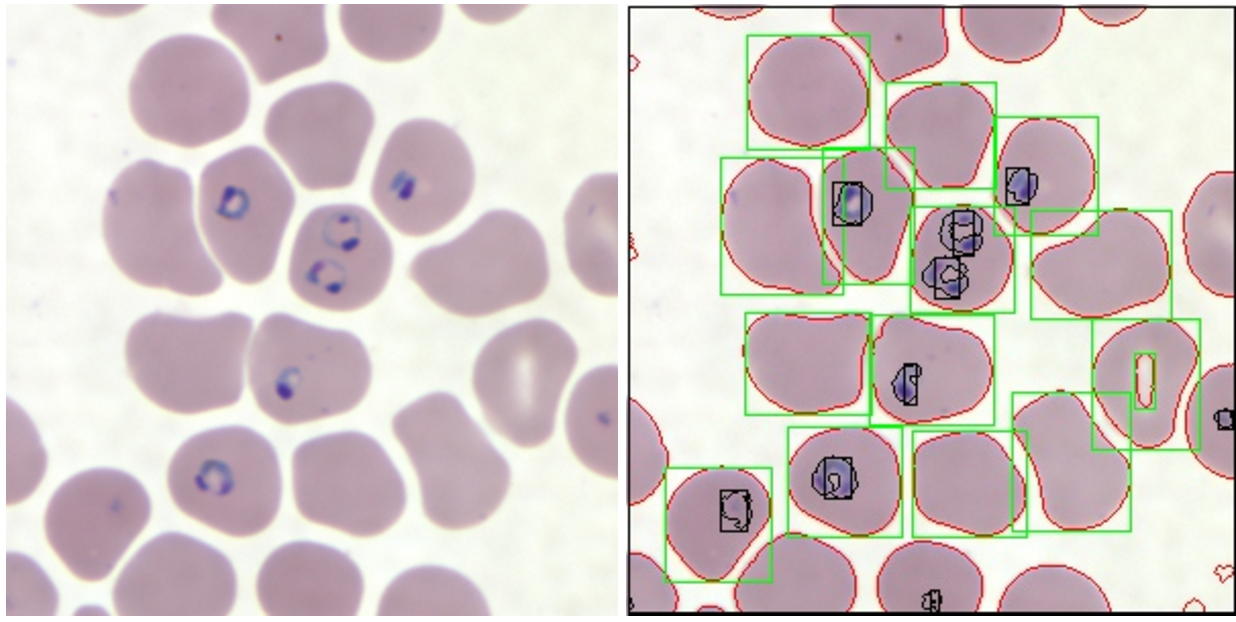
fuMalaria.com gallery image

fuMalaria.com
Open Source Malaria Detection Computer Vision Prototype
0 followers
Open Source Malaria Detection Computer Vision Prototype
0 followers

Launch Team
Anima - OnBrand Vibe Coding — Design-aware AI for modern product teams.
Design-aware AI for modern product teams.
Promoted
Maker
Report
